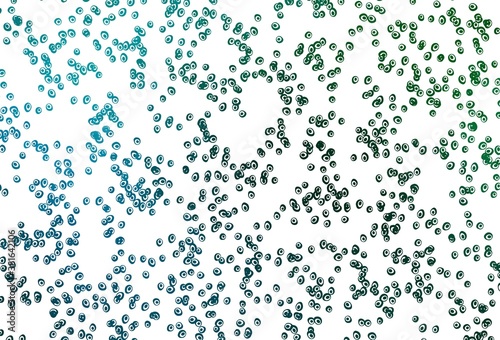
Light Blue, Green vector cover with spots.

More from this collection

Dots Pop Art Halftone With Red Background Modern Art Banner Template Future Technology Concept Design, Halftone Dots Red And White Color Pattern Gradient Grunge Dotted Texture Effect Background.

Light Frame Liquid Glass Texture With Soft Effect Modern Transparent Frame Shapes For Design And Morphism Style Glossy Interface, Liquid Glass Panels And Elements Set With Difference Type Of Shape.

Dots Pop Art Halftone With Red Background Modern Art Banner Template Future Technology Concept Design, Halftone Dots Red And White Color Pattern Gradient Grunge Dotted Texture Effect Background.

Abstract Pixeled Bar Colorful Background With Squares And Rectangles Futuristic Pixel Illustration, Abstract Texture Of Modern Geometric Pattern Design Squares Background.

Modern And Trendy Abstract Smooth Color Design Minimal Red And White Halftone Gradient Vector With Dotted Texture Background, Halftone Patterns Creating Textured Design For Dynamic Red Background.
View All from Collection
Explore more designs